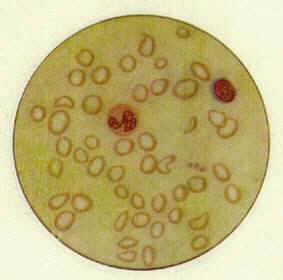
ϸС

六、治疗
(一)一般治疗及改善饮食 如系母乳喂养儿,应改善乳母的膳食营养,婴儿还须添加辅食,按时断奶,纠正偏食习惯。积极予防和治疗呼吸道和消化道疾病。
(二)药物治疗
主要应用维生素B12100μg/次 每周肌注2次,连续2-4周,直至网织红细胞正常、已能配合添加辅食为止。
对叶酸缺乏者。口服叶酸5mg每日3次,连用2周后,可改每日1次。维生素C能促进叶酸的利用,可同时口服,以提高疗效。
目前主张维生素B12和叶酸联合应用,再加服维生素C,可提高疗效。应用维生素B12和/或叶酸合治疗3-4天后,一般精神神经症状好转,网织细胞开始增加,6-7天达高峰(15-16%),2周后降至正常,2-6周红细胞和血红蛋白恢复正常,骨髓巨幼红细胞可于维生素B12治疗3-72小时后。叶酸治疗24-48小时后,转为正常。但巨幼粒和分叶过多的巨核细胞可能存在数天。神经系统恢复较慢,少量患者需经数月后才能完全qe消失。
图6-6 注:红细胞大小不等
营养性小细胞性贫 ,小的偏多中空明显,
血血象(1) 形态不下整。
1.中性分叶粒细胞 2.淋巴细胞 3.血小板

图6―7 营养性小细胞性贫血骨髓象(1)
1.早幼红细胞 2.中幼红细胞3.晚幼红细胞
4.早幼粒细胞5.中性中幼粒细胞6.中性晚幼粒细胞7.中性杆状粒细胞
8.中性分叶粒细胞 9.淋巴细胞10.血小板
注:中幼红细胞增多,胞体小,胞浆嗜石碱性强。

图6―8 营养性大细胞必贫血血象(1)
1.中性分叶粒细胞 2.淋巴细胞 3.血小板 4.巨血小板
注:红细胞轻度大小不等大的偏多血红蛋白饱满.中性分叶粒细胞较大,核分叶趋势偏多(核右移)。

图6―9 营养性大细胞性贫血骨髓象
注:原红细胞及早幼红细胞细胞数增加,胞体增大,胞核染色质粗、松
1.原红细胞 2.早幼红细胞 3.中幼红细胞
4.晚幼红细胞[其中一个含豪-若氏(Howell-Jolly)小体]
5.分裂型红细胞
6.嗜碱性点彩红细胞 7.原粒细胞 8.是幼粒细胞9.中性晚幼粒细胞
10.中必晚幼粒细胞11.中性杆状粒细胞12.中性分叶粒细胞
13.嗜酸性晚幼粒细胞 14.淋巴细胞 15.血小板16.巨血小板
(三)对症治疗
发生震颤者应给少量镇静剂。如震颤影响呼吸者应给氧气吸入。
| 上一页:五、诊断 |
| 当前页:六、治疗 |
| 下一页:[附] 铁缺乏 |